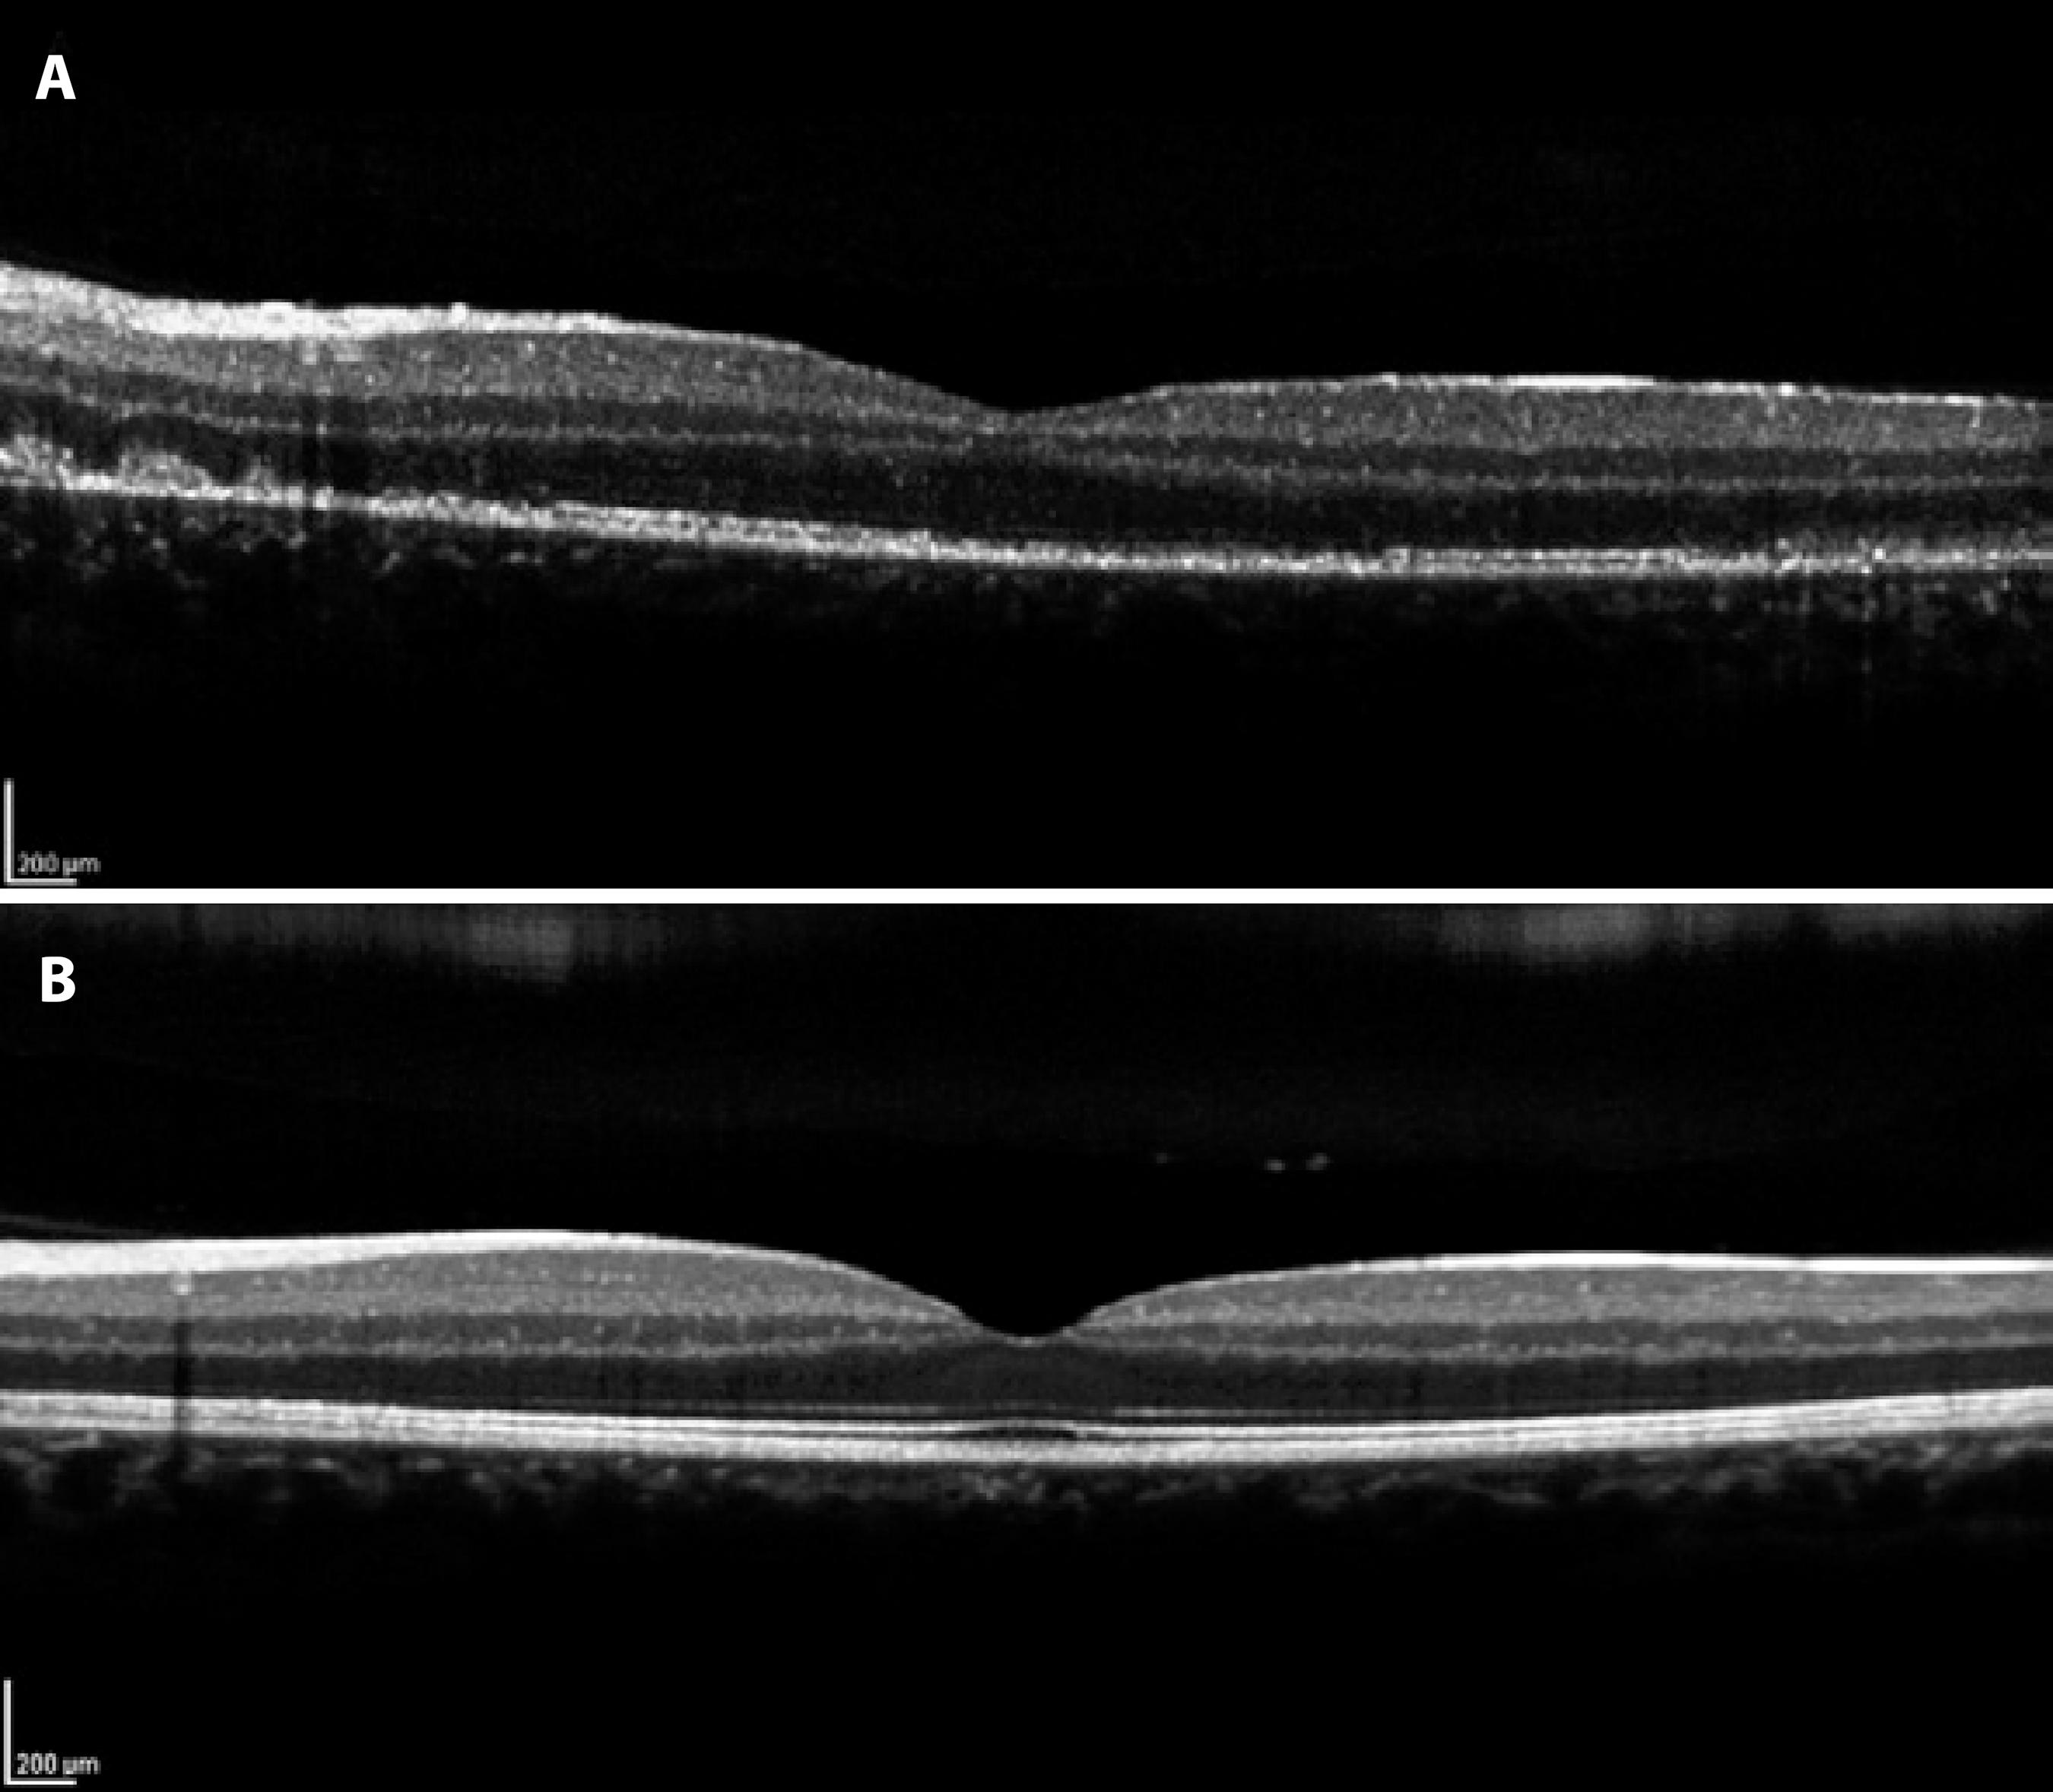

INTRODUCTION
Multiple evanescent white dot syndrome (MEWDS) is a benign self-healing disease with an unknown etiology that was first described in 1984 by Jampol et al. It is a retinal pigment epithelial (RPE) and choroidal inflammatory condition that predominantly affects young to middle-aged women, is unilateral in 80% of cases, and causes visual loss of variable degrees(1-5).
Associated clinical features include flu-like prodrome, blurred disc margins, blind spot enlargement, and temporal scotomata(2,5). Fundoscopy typically reveals multiple, 100-200 µm yellow-white outer retina dots in posterior pole and mid-periphery as well as a unique foveal granularity(1,2,4-7).
Fluorescein angiography (FA) typical aspect comprises early foveal granular hyperfluorescence, early hyperfluorescence, and late staining of the white dots in a wreath-like pattern and disc capillary leakage. Indocyanine green angiography (ICGA) shows numerous hypofluorescent nummular lesions that are evident in the late phase and predominant in the mid-periphery and around the optic disc(2,4,7).
Here, we report a case of MEWDS notable for its classic retinal appearance, foveal granularity, and transient disruption of the macular photoreceptor of the inner segment-outer segment (IS-OS) junction. After six months of follow up, the patient presented full visual recovery and re-established a normal foveal aspect on Spectral Domain Optical Coherence Tomography (SD-OCT).
CASE REPORT
A 20-year-old man presented for an ophthalmologic evaluation with a 2-day history of blurred vision in his left eye and flu-like symptoms that began 1 week before the visual symptoms started. His best-corrected visual acuity was 20/20 (OD) and 20/40 (OS); intraocular pressure was 15 mmHg in OU. Anterior biomicroscopy was normal in OU. Fundus examination was normal in OD, and OS revealed multiple 100-500 µm yellow-white dots deep to the retina in the posterior pole and mid-periphery, foveal granularity, and blurred disc margins (Figure 1).

Figure 1 A) Retinography demonstrating normal foveal aspect in the right eye. B) Retinography demonstrating foveal granularity in the left eye.
Automated perimetry showed a blind spot enlargement in the affected eye. FA had shown earlier hyperfluorescent lesions in the posterior pole and mid-periphery, with late staining of the white dots in a wreath-like pattern and late staining in the optic nerve (Figure 2). The corresponding ICGA demonstrated numerous hypofluorescent areas predominantly in the mid-periphery and around the optic disc. These hypofluorescent areas were mild and in an early angiographic phase, but became more clearly delineated in the late phase (Figure 2). SD-OCT showed mild attenuation of the external limiting membrane, a transient disruption of the macular photoreceptor IS-OS junction, increased RPE reflectivity and enhanced signal penetration into the underlying choroid (Figure 3). The patient was diagnosed with MEWDS and observation without treatment was suggested. The patient was lost at follow-up, but returned 24 weeks later after contacting the authors. He claimed that he had not attended the visits because he had visual recovery within one month. His BCVA was 20/20 OU. Fundus examination in the OD was normal, and the OS revealed mild foveal granularity and RPE hyperpigmentation surrounding the optic disc. Color and red-free fundus photography showed the retinal white dots disappeared. SD-OCT indicated the IS-OS disruption resolved with reestablishment of outer retina OCT anatomy (Figure 3).

Figure 2 Multiple evanescent white dot syndrome lesions. A) Fluorescein angiography demonstrating early hyperfluorescent lesions. B) Fluorescein angiography, in late stage, demonstrating staining of the white dots in a wreath-like pattern and disc capillary leakage. C) Indocyanine green angiography, in the early phase, showing discrete hypofluorescent nummular lesions. D) Indocyanine green angiography (late phase) showing numerous clearly delineated hypofluorescent nummular lesions.
Figure 3 A) Spectral Domain Optical Coherence Tomography (SD-OCT) demonstrating mild attenuation of the external limiting membrane, disruption of the macular photoreceptor inner segment-outer segment (IS-OS) junction, and increased RPE reflectivity. B) SD-OCT demonstrating resolution of IS-OS disruption with reestablishment of outer retina OCT anatomy.
DISCUSSION
MEWDS is an acute, usually unilateral retinopathy that predominantly affects macular and mid-periphery regions of young women, causing mild to moderate visual loss. Characteristic symptoms include photopsia, and a viral prodrome is reported in 50% of the cases. In this case report, the patient was a young male who had unilateral visual loss. He had flu-like symptoms 1 week before the initial evaluation, and did not present with photopsia(1,2).
In the present case, FA demonstrated typical early hyperfluorescence with late RPE staining, corresponding to hypofluorescent areas in the late phase of ICGA(1,5). These hypofluorescent areas showed moderately reflective focal lesions in the outer photoreceptor layer, where the macular photoreceptor IS-OS junction was disrupted by SD-OCT, which is associated with foveal granularity. Possibly, the foveal granularity is the most specific characteristic of MEWDS(1,4,8,9).
Considering the clinical and angiographic pattern, and through electrophysiological evidence, previous studies have suggested that the white dot lesions in MEWDS are situated in the RPE and outer retina. Electrophysiology analysis has revealed an electro-oculographic reduction in the light-dark ratio, and an electroretinographic alteration of the a-wave and early receptor potential(6,8).
Ophthalmologic studies have advocated the hypothesis that injury to the RPE is the early pathologic event in MEWDS. FA showed characteristic early hyperfluorescent lesions that were observed as window defects. It was suggested the primary site of MEWDS is on the RPE(2,6). With the clinical use of ICGA, MEWDS has become known as a choroidopathy, suggesting that the cause of the photoreceptors and RPE dysfunction is associated to decreased perfusion of the choriocapillaris(4-6,10). This supposition is based on their angiographic pattern that demonstrated hypofluorescent lesions on ICGA that may appear even in normal areas on FA and funduscopy(6).
In the case reported here, the FA pattern demonstrated characteristic early hyperfluorescence and late staining, which appeared to be due to RPE changes; however, the ICGA showed numerous hypofluorescent areas mainly in the mid-periphery. These hypofluorescent areas are mild in initial angiographic phases and become more evidently delineated in the late phase, which appears to slightly outnumber those observed on FA, suggesting that MEWDS involves both RPE and choriocapillay(2,8).
In this case ICGA was not crucial to diagnosis, because of other classic findings, but it was useful to confirm diagnosis and also in differential diagnosis with other white dot syndromes. Acute posterior multifocal placoid pigment epitheliopathy (APMPPE) has been considered an important differential diagnosis. FA patterns in APMPPE show early hypofluorescence, but become hyperfluorescent later in the study. In ICGA, lesions present as early to late hypofluorescence.
MEWDS has been considered the first known disease involving electrophysiological damage of photoreceptor outer segments with complete return to normal conditions(8). We report a case of MEWDS notable for both its classic retinal appearance, confirmed by automated perimetry, FA, ICGA, and SD-OCT exams. SD-OCT has showed disruption of the IS-OS junction. The patient was observed with no medical intervention, and had a favorable recovery of visual function and macular photoreceptor IS-OS junction in SD-OCT. This is consistent with previous report and OCT findings about the disease.
English PDF
Print
Send this article by email
How to cite this article
Submit a comment
Mendeley
Scielo
Pocket
Share on Linkedin

